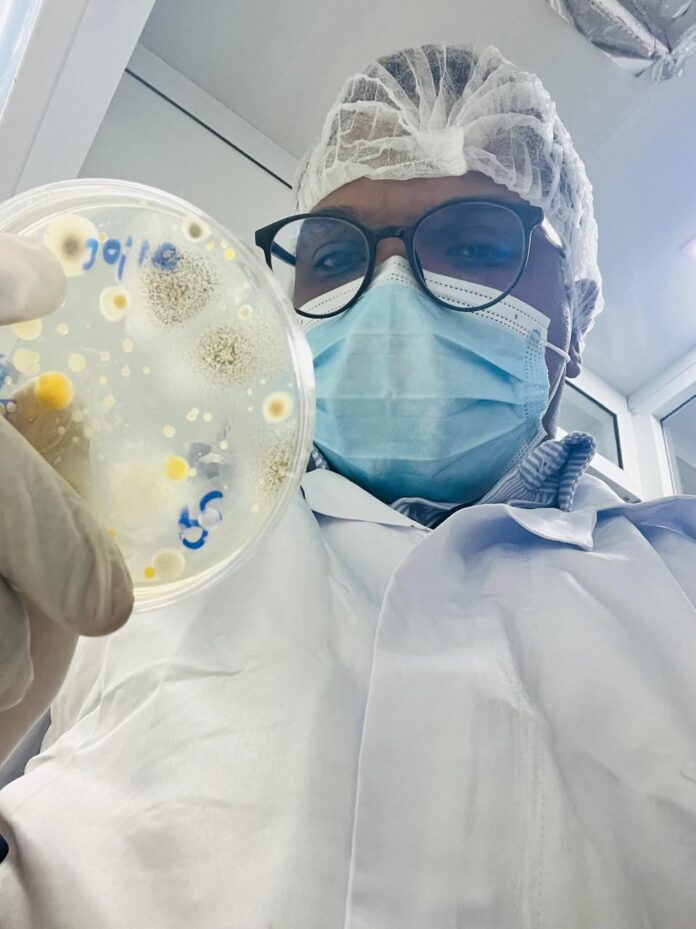

Por Starling Villar
-Microbiologo de la UASD.
-Auxiliar de Investigación CIBIMA IBC.
-Analista de microbiología y control ambiental en Boe dominicana.
En el sector industrial, especialmente en aquellos relacionados con la producción de alimentos, medicamentos y productos regulados, el departamento de Calidad juega un papel fundamental. Dentro de este departamento, existen roles especializados que, aunque interconectados, tienen funciones claramente distintas. En este artículo, exploraremos las diferencias y funciones de un Inspector de Calidad, un Analista de Calidad y un Analista de Microbiología.
El Inspector de Calidad es responsable de verificar en tiempo real que los procesos y materiales cumplan con los procedimientos establecidos. Su labor es operativa y visual, centrada en prevenir desviaciones y garantizar que los productos se fabriquen según los estándares de calidad. Por otro lado, el Analista de Calidad se enfoca en realizar pruebas físico-químicas para caracterizar los productos y determinar si cumplen con las especificaciones establecidas. Su trabajo es fundamental para garantizar la calidad y seguridad de los productos.
El Analista de Microbiología, por su parte, se especializa en asegurar la esterilidad y controlar la carga microbiana de los productos. Su expertise es crucial para prevenir riesgos biológicos y garantizar la seguridad del usuario. En conjunto, estos tres roles forman un sistema de control integral que garantiza la calidad y seguridad de los productos.
Aunque un Analista de Calidad o Microbiología pueden realizar las funciones de un Inspector de Calidad(en el último caso), lo ideal es que, cada profesional esté en su posición de especialización ya que esto provoca explotar su potencial académica al máximo.
Es importante tener presente que en la República Dominicana, la industria farmacéutica y alimentaria es un sector clave para la economía del país. La implementación de roles como el Inspector de Calidad, el Analista de Calidad y el Analista de Microbiología es fundamental para garantizar la calidad y seguridad de los productos que se producen y comercializan en el país.
En conclusión, la capacitación y especialización de estos profesionales es esencial para mantener los estándares de calidad y competitividad en el mercado nacional e internacional.